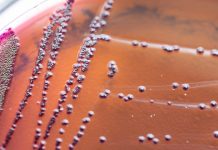
Research: The extraordinary powers of bacteria visualized in real time —

Research: Older male crickets attract more females — but mate less —
Older male crickets are better at getting females to live with them -- but they mate less than younger rivals once they find...
Research: An analysis of the alpine marmot’s genome —
What effects does climate change have on the genetic diversity of living organisms? In a study led by Charité -- Universitätsmedizin Berlin, an...
Research: How corn’s ancient ancestor rejects crossbreeding —
Determining how one species becomes distinct from another has been a subject of fascination dating back to Charles Darwin. New research led by...
Research: An exotic species threatening local fish —
Preventing the introduction of the mosquitofish and removing its population are the most effective actions to control the dispersal of this exotic fish...
Research: Origami-inspired materials could soften the blow for reusable spacecraft —
Space vehicles like SpaceX's Falcon 9 are designed to be reusable. But this means that, like Olympic gymnasts hoping for a gold medal,...
Research: Exotic matter uncovered in the sun’s atmosphere —
Scientists from Ireland and France have announced a major new finding about how matter behaves in the extreme conditions of the Sun's atmosphere.
The...
Research: Scientists create new standard genome for heavily studied worm —
A new Cornell University-led study finds that the genome for a widely researched worm, on which countless studies are based, was flawed. Now,...
Research: Work has implications for health across species as fluctuations in body temperature may...
Can the environment affect how the spinal cord develops specialized circuitry, or is that process hardwired, following prescribed genetic instructions turned on early...
Research: Mites and ticks are close relatives, new research shows —
Scientists from the University of Bristol and the Natural History Museum in London have reconstructed the evolutionary history of the chelicerates, the mega-diverse...
Research: The extraordinary powers of bacteria visualized in real time —
The global spread of antibiotic resistance is a major public health issue and a priority for international microbiology research. In his paper to...
Top News
Hey ISIS, You Suck: Local Muslims Post Anti-ISIS Billboard
A new billboard on Manchester Road in Missouri reads, "HEY ISIS, YOU SUCK!!! From: #ActualMuslims."
A group of Muslim-Americans have put up a blunt billboard...